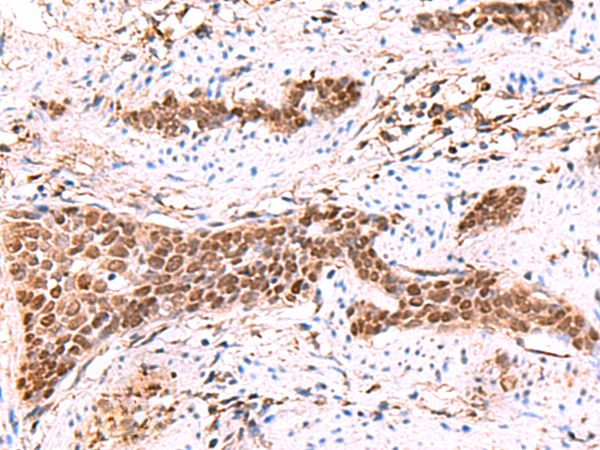

|
Background: |
This intronless gene encodes a member of the SRY-related HMG-box (SOX) family of transcription factors involved in the regulation of embryonic development and in the determination of cell fate. The product of this gene is required for stem-cell maintenance in the central nervous system, and also regulates gene expression in the stomach. Mutations in this gene have been associated with optic nerve hypoplasia and with syndromic microphthalmia, a severe form of structural eye malformation. This gene lies within an intron of another gene called SOX2 overlapping transcript (SOX2OT). |
|
Applications: |
ELISA, WB, IHC |
|
Name of antibody: |
SOX2 |
|
Immunogen: |
Synthetic peptide of human SOX2 |
|
Full name: |
SRY-box 2 |
|
Synonyms: |
ANOP3; MCOPS3 |
|
SwissProt: |
P48431 |
|
ELISA Recommended dilution: |
5000-10000 |
|
IHC positive control: |
Human tonsil and Human esophagus cancer |
|
IHC Recommend dilution: |
30-150 |
|
WB Predicted band size: |
34 kDa |
|
WB Positive control: |
Hela, 293T and HepG2 cell lysates |
|
WB Recommended dilution: |
1000-5000 |

購物車
幫助
021-54845833/15800441009
